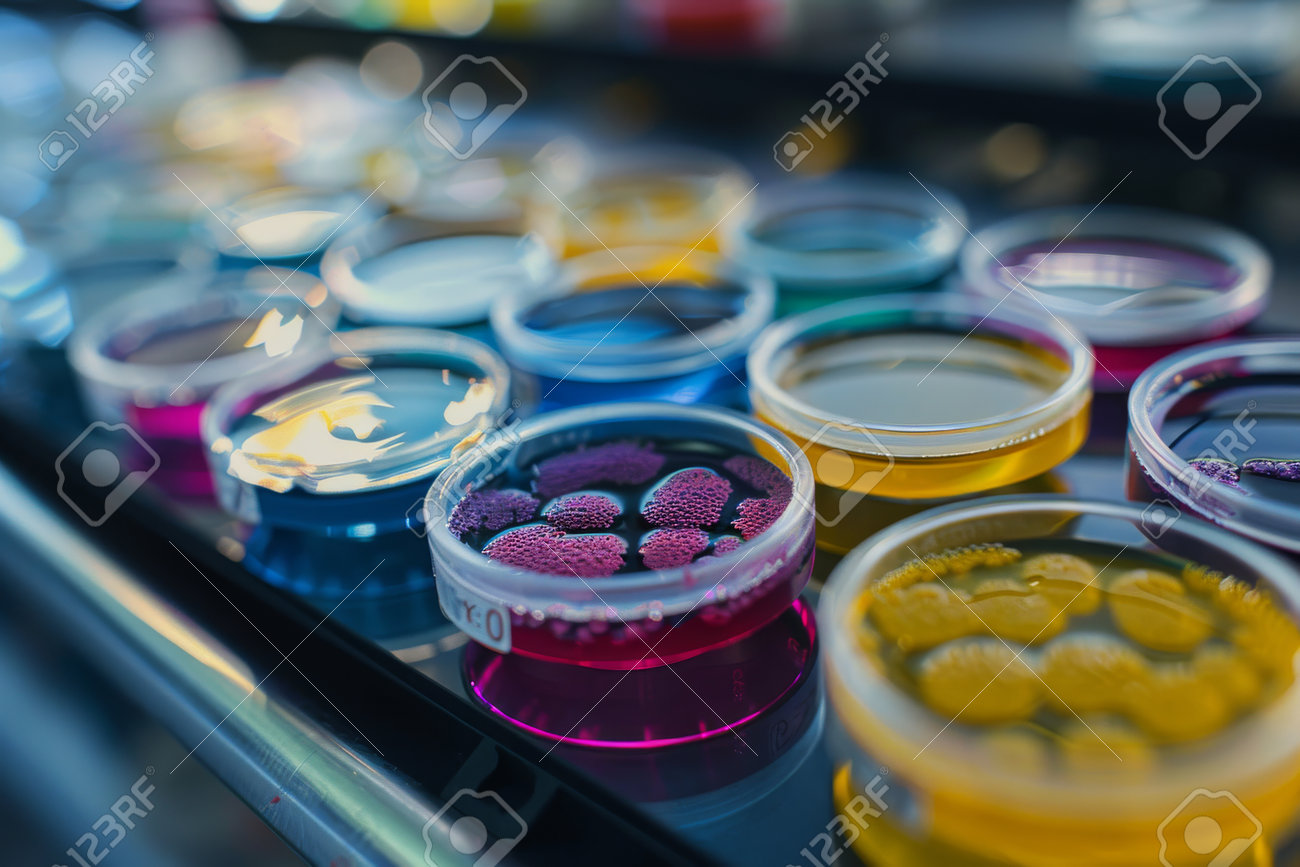
etiam-dictum-ipsum-a-felis

Download
Close
Автор:
id:
Ключевые слова:
analysis, arab, awareness, backgrounds, bacterium, biochemistry, biology, biotechnology, chart, clinic, clinical, colony, concentration, crisis, data, disease, disposal, drug, epidemic, evolution, experiment, genetic, growth, health care, illustration, infection, isolated, lab, laboratory, medical, medicine, microbiology, microscope, mutation, no people, pandemic, petri, pharmaceutical, pill, prevention, research, resistance, sample, science, scientific, test, treatment, vaccine, virus, white,





